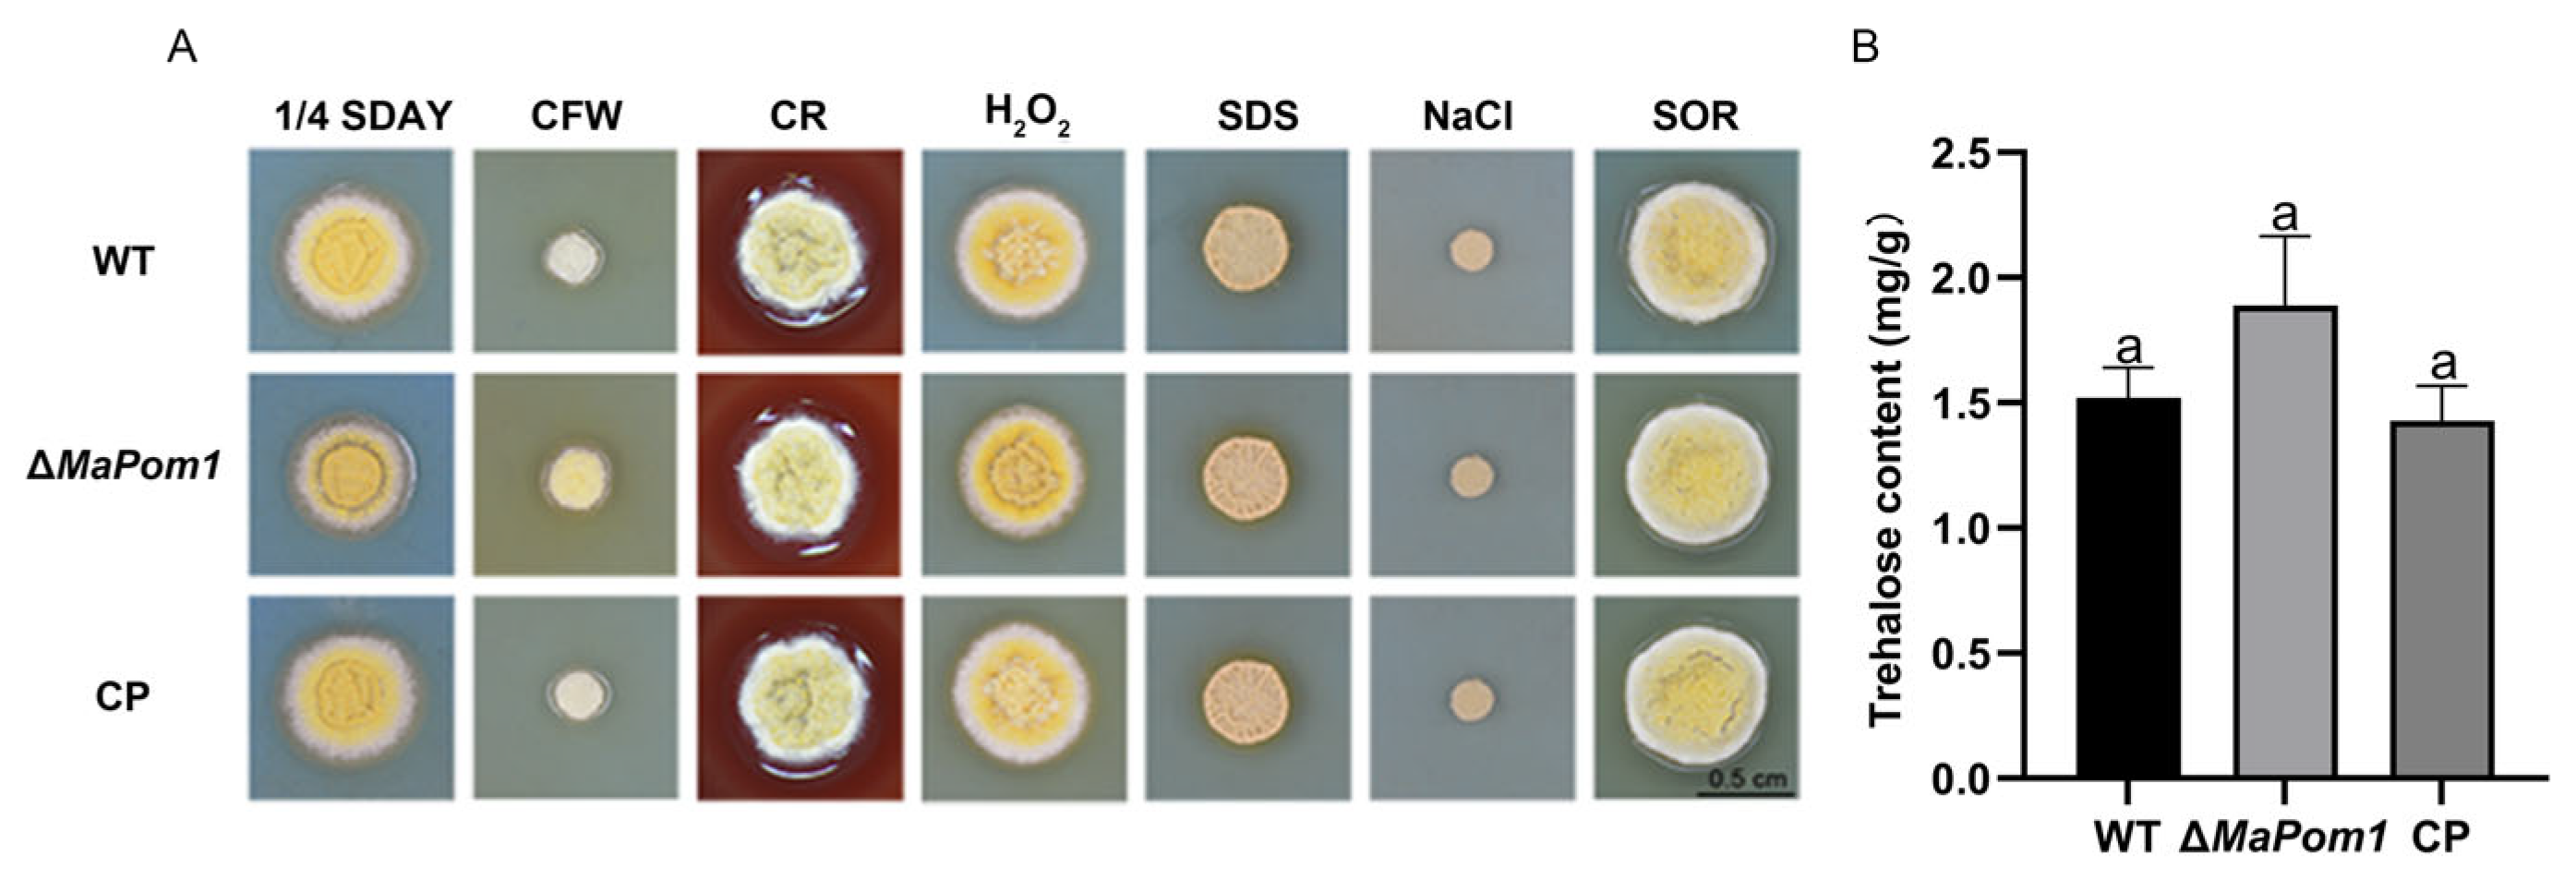
Ijms 25 11860 g006

MaPom1, a Dual-Specificity Tyrosine Phosphorylation-Regulated Kinase, Positively Regulates Thermal and UV-B Tolerance in Metarhizium acridum
Abstract
1. Introduction
2. Results
2.1. Characteristics of MaPom1
2.2. MaPom1 Contributes to Conidial Germination and Mycelial Growth with No Effect on Conidial Yield and Virulence
2.3. MaPom1 Is Essential for Thermal and UV-B Tolerance
2.4. Identification of DEGs Influenced by MaPom1
2.5. MaPom1 Contributes to Stress Tolerance Independently of Cell Wall Composition
2.6. MaPom1 Contributes to UV-B Tolerance by Regulating DNA Damage Repair
3. Discussion
3.1. MaPom1 Affects Conidial Germination but Not Virulence and Conidial Yield
3.2. MaPom1 Positively Regulates UV-B and Thermal Tolerance Not via Cell Wall Composition
3.3. MaPom1 Affects UV-B Tolerance via Regulating the Transcription Level of DNA Damage and Repair Genes
3.4. MaPom1 Affects Thermal Tolerance via Regulating the Transcription Level of HSPs
4. Materials and Methods
4.1. Strains and Cultivation Conditions
4.2. Bioinformatic Analysis
4.3. Construction of MaPom1 Mutants
4.4. Southern Blotting
4.5. Quantitative Reverse Transcription PCR (qRT-PCR)
4.6. Serine/Threonine Kinase Activity Analysis
4.7. Microscopic Investigation and Fluorescence Staining
4.8. Conidial Germination and Conidial Yield Assays
4.9. Virulence Assays
4.10. Stress Tolerance Assays
4.11. Trehalose Extraction and Quantification Assays
4.12. Digital Gene Expression Profiling (DGE)
4.13. Data Analysis
5. Conclusions
Supplementary Materials
Author Contributions
Funding
Institutional Review Board Statement
Informed Consent Statement
Data Availability Statement
Acknowledgments
Conflicts of Interest
References
- Krupa, S.V.; Kickert, R.N. The Greenhouse effect: Impacts of ultraviolet-B (UV-B) radiation, carbon dioxide (CO2), and ozone (O3) on vegetation. Environ. Pollut. 1989, 61, 263–393. [Google Scholar] [CrossRef] [PubMed]
- Zepp, R.G.; Erickson, D.J., 3rd; Paul, N.D.; Sulzberger, B. Effects of solar UV radiation and climate change on biogeochemical cycling: Interactions and feedbacks. Photochem. Photobiol. Sci. 2011, 10, 261–279. [Google Scholar] [CrossRef] [PubMed]
- Deutsch, C.A.; Tewksbury, J.J.; Tigchelaar, M.; Battisti, D.S.; Merrill, S.C.; Huey, R.B.; Naylor, R.L. Increase in crop losses to insect pests in a warming climate. Science 2018, 361, 916–919. [Google Scholar] [CrossRef] [PubMed]
- Fadiji, A.E.; Yadav, A.N.; Santoyo, G.; Babalola, O.O. Understanding the plant-microbe interactions in environments exposed to abiotic stresses: An overview. Microbiol. Res. 2023, 271, 127368. [Google Scholar] [CrossRef]
- Coleine, C.; Stajich, J.E.; Selbmann, L. Fungi are key players in extreme ecosystems. Trends Ecol. Evol. 2022, 37, 517–528. [Google Scholar] [CrossRef]
- Deka, B.; Baruah, C.; Babu, A. Entomopathogenic microorganisms: Their role in insect pest management. Egypt. J. Biol. Pest Control 2021, 31, 121. [Google Scholar] [CrossRef]
- Chen, W.; Xie, W.; Cai, W.; Thaochan, N.; Hu, Q. Entomopathogenic Fungi Biodiversity in the Soil of Three Provinces Located in Southwest China and First Approach to Evaluate Their Biocontrol Potential. J. Fungi 2021, 7, 984. [Google Scholar] [CrossRef]
- Roberts, D.W.; St. Leger, R.J. Metarhizium spp., cosmopolitan insect-pathogenic fungi: Mycological aspects. Adv. Appl. Microbiol. 2004, 54, 1–70. [Google Scholar]
- Guerrero-Guerra, C.; Reyes-Montes, M.d.R.; Toriello, C.; Hernández-Velázquez, V.; Santiago-López, I.; Mora-Palomino, L.; Calderón-Segura, M.E.; Fernández, S.D.; Calderón-Ezquerro, C. Study of the persistence and viability of Metarhizium acridum in Mexico’s agricultural area. Aerobiologia 2013, 29, 249–261. [Google Scholar] [CrossRef]
- Fravel, D.R. Commercialization and Implementation of Biocontrol. Annu. Rev. Phytopathol. 2005, 43, 337–359. [Google Scholar] [CrossRef]
- Kumamoto, C.A. Molecular mechanisms of mechanosensing and their roles in fungal contact sensing. Nat. Rev. Microbiol. 2008, 6, 667–673. [Google Scholar] [CrossRef] [PubMed]
- Brown, A.J.; Haynes, K.; Quinn, J. Nitrosative and oxidative stress responses in fungal pathogenicity. Curr. Opin. Microbiol. 2009, 12, 384–391. [Google Scholar] [CrossRef] [PubMed]
- Braga, G.U.L.; Rangel, D.E.N.; Fernandes, É.K.K.; Flint, S.D.; Roberts, D.W. Molecular and physiological effects of environmental UV radiation on fungal conidia. Curr. Genet. 2015, 61, 405–425. [Google Scholar] [CrossRef] [PubMed]
- Papagianni, M. Fungal morphology and metabolite production in submerged mycelial processes. Biotechnol. Adv. 2004, 22, 189–259. [Google Scholar] [CrossRef] [PubMed]
- Chandler, D. Chapter 5—Basic and Applied Research on Entomopathogenic Fungi. In Microbial Control of Insect and Mite Pests; Lacey, L.A., Ed.; Academic Press: New York, NY, USA, 2017; pp. 69–89. [Google Scholar]
- Alali, S.; Mereghetti, V.; Faoro, F.; Bocchi, S.; Al Azmeh, F.; Montagna, M. Thermotolerant isolates of Beauveria bassiana as potential control agent of insect pest in subtropical climates. PLoS ONE 2019, 14, e0211457. [Google Scholar] [CrossRef]
- Ortiz-Urquiza, A.; Luo, Z.; Keyhani, N.O. Improving mycoinsecticides for insect biological control. Appl. Microbiol. Biotechnol. 2015, 99, 1057–1068. [Google Scholar] [CrossRef]
- Zhang, L.-B.; Feng, M.-G. Antioxidant enzymes and their contributions to biological control potential of fungal insect pathogens. Appl. Microbiol. Biotechnol. 2018, 102, 4995–5004. [Google Scholar] [CrossRef]
- Rangel, D.E.N.; Alder-Rangel, A.; Dadachova, E.; Finlay, R.D.; Kupiec, M.; Dijksterhuis, J.; Braga, G.U.L.; Corrochano, L.M.; Hallsworth, J.E. Fungal stress biology: A preface to the Fungal Stress Responses special edition. Curr. Genet. 2015, 61, 231–238. [Google Scholar] [CrossRef]
- Abu Bakar, N.; Karsani, S.A.; Alias, S.A. Fungal survival under temperature stress: A proteomic perspective. PeerJ 2020, 8, e10423. [Google Scholar] [CrossRef]
- Kciuk, M.; Marciniak, B.; Mojzych, M.; Kontek, R. Focus on UV-Induced DNA Damage and Repair-Disease Relevance and Protective Strategies. Int. J. Mol. Sci. 2020, 21, 7264. [Google Scholar] [CrossRef]
- Gao, L.; Liu, Y.; Sun, H.; Li, C.; Zhao, Z.; Liu, G. Advances in mechanisms and modifications for rendering yeast thermotolerance. J. Biosci. Bioeng. 2016, 121, 599–606. [Google Scholar] [CrossRef] [PubMed]
- Moraitis, C.; Curran, B.P. Reactive oxygen species may influence the heat shock response and stress tolerance in the yeast Saccharomyces cerevisiae. Yeast 2004, 21, 313–323. [Google Scholar] [CrossRef] [PubMed]
- Goldman, G.H.; McGuire, S.L.; Harris, S.D. The DNA damage response in filamentous fungi. Fungal Genet. Biol. 2002, 35, 183–195. [Google Scholar] [CrossRef] [PubMed]
- Goldman, G.H.; Kafer, E. Aspergillus nidulans as a model system to characterize the DNA damage response in eukaryotes. Fungal Genet. Biol. 2004, 41, 428–442. [Google Scholar] [CrossRef] [PubMed]
- Hu, C.; Yang, J.; Qi, Z.; Wu, H.; Wang, B.; Zou, F.; Mei, H.; Liu, J.; Wang, W.; Liu, Q. Heat shock proteins: Biological functions, pathological roles, and therapeutic opportunities. MedComm 2022, 3, e161. [Google Scholar] [CrossRef]
- Tiwari, S.; Thakur, R.; Shankar, J. Role of Heat-Shock Proteins in Cellular Function and in the Biology of Fungi. Biotechnol. Res. Int. 2015, 2015, 132635. [Google Scholar] [CrossRef]
- Xiao, W.; Zhang, J.; Huang, J.; Xin, C.; Li, M.J.; Song, Z. Response and regulatory mechanisms of heat resistance in pathogenic fungi. Appl. Microbiol. Biotechnol. 2022, 106, 5415–5431. [Google Scholar] [CrossRef]
- Fabri, J.; Rocha, M.C.; Fernandes, C.M.; Persinoti, G.F.; Ries, L.N.A.; da Cunha, A.F.; Goldman, G.H.; Del Poeta, M.; Malavazi, I. The Heat Shock Transcription Factor HsfA Is Essential for Thermotolerance and Regulates Cell Wall Integrity in Aspergillus fumigatus. Front. Microbiol. 2021, 12, 656548. [Google Scholar] [CrossRef]
- Rangel, D.E.; Butler, M.J.; Torabinejad, J.; Anderson, A.J.; Braga, G.U.; Day, A.W.; Roberts, D.W. Mutants and isolates of Metarhizium anisopliae are diverse in their relationships between conidial pigmentation and stress tolerance. J. Invertebr. Pathol. 2006, 93, 170–182. [Google Scholar] [CrossRef]
- Pawson, T.; Scott, J.D. Protein phosphorylation in signaling—50 years and counting. Trends Biochem. Sci. 2005, 30, 286–290. [Google Scholar] [CrossRef]
- Roskoski, R., Jr. A historical overview of protein kinases and their targeted small molecule inhibitors. Pharmacol. Res. 2015, 100, 1–23. [Google Scholar] [CrossRef] [PubMed]
- Pang, K.; Wang, W.; Qin, J.X.; Shi, Z.D.; Hao, L.; Ma, Y.Y.; Xu, H.; Wu, Z.X.; Pan, D.; Chen, Z.S.; et al. Role of protein phosphorylation in cell signaling, disease, and the intervention therapy. MedComm 2022, 3, e175. [Google Scholar] [CrossRef] [PubMed]
- Seumen, C.H.T.; Grimm, T.M.; Hauck, C.R. Protein phosphatases in TLR signaling. Cell Commun. Signal. 2021, 19, 45. [Google Scholar] [CrossRef] [PubMed]
- Cross, T.G.; Scheel-Toellner, D.; Henriquez, N.V.; Deacon, E.; Salmon, M.; Lord, J.M. Serine/threonine protein kinases and apoptosis. J. Tradit. Chin. Med. 2000, 256, 34–41. [Google Scholar] [CrossRef] [PubMed]
- Liu, C.Y.; Liu, W.; Zhao, W.L.; Wang, J.X.; Zhao, X.F. Upregulation of the expression of prodeath serine/threonine protein kinase for programmed cell death by steroid hormone 20-hydroxyecdysone. Apoptosis 2013, 18, 171–187. [Google Scholar] [CrossRef]
- Durán, R.; Villarino, A.; Bellinzoni, M.; Wehenkel, A.; Fernandez, P.; Boitel, B.; Cole, S.T.; Alzari, P.M.; Cerveñansky, C. Conserved autophosphorylation pattern in activation loops and juxtamembrane regions of Mycobacterium tuberculosis Ser/Thr protein kinases. Biochem. Biophys. Res. Commun. 2005, 333, 858–867. [Google Scholar] [CrossRef]
- Faucher, S.P.; Viau, C.; Gros, P.P.; Daigle, F.; Le Moual, H. The prpZ gene cluster encoding eukaryotic-type Ser/Thr protein kinases and phosphatases is repressed by oxidative stress and involved in Salmonella enterica serovar Typhi survival in human macrophages. FEMS Microbiol. Lett. 2008, 281, 160–166. [Google Scholar] [CrossRef]
- Pereira, S.F.; Goss, L.; Dworkin, J. Eukaryote-like serine/threonine kinases and phosphatases in bacteria. Microbiol. Mol. Biol. Rev. 2011, 75, 192–212. [Google Scholar] [CrossRef]
- Boni, J.; Rubio-Perez, C.; López-Bigas, N.; Fillat, C.; de la Luna, S. The DYRK Family of Kinases in Cancer: Molecular Functions and Therapeutic Opportunities. Cancers 2020, 12, 2106. [Google Scholar] [CrossRef]
- Rammohan, M.; Harris, E.; Bhansali, R.S.; Zhao, E.; Li, L.S.; Crispino, J.D. The chromosome 21 kinase DYRK1A: Emerging roles in cancer biology and potential as a therapeutic target. Oncogene 2022, 41, 2003–2011. [Google Scholar] [CrossRef]
- Laham, A.J.; Saber-Ayad, M.; El-Awady, R. DYRK1A: A down syndrome-related dual protein kinase with a versatile role in tumorigenesis. Cell. Mol. Life Sci. 2021, 78, 603–619. [Google Scholar] [CrossRef] [PubMed]
- Martin, S.G.; Berthelot-Grosjean, M. Polar gradients of the DYRK-family kinase Pom1 couple cell length with the cell cycle. Nature 2009, 459, 852–856. [Google Scholar] [CrossRef] [PubMed]
- Garrett, S.; Menold, M.M.; Broach, J.R. The Saccharomyces cerevisiae YAK1 gene encodes a protein kinase that is induced by arrest early in the cell cycle. Mol. Cell. Biol. 1991, 11, 4045–4052. [Google Scholar] [PubMed]
- Aranda, S.; Laguna, A.; de la Luna, S. DYRK family of protein kinases: Evolutionary relationships, biochemical properties, and functional roles. FASEB J. 2011, 25, 449–462. [Google Scholar] [CrossRef] [PubMed]
- Bähler, J.; Pringle, J.R. Pom1p, a fission yeast protein kinase that provides positional information for both polarized growth and cytokinesis. Genes Dev. 1998, 12, 1356–1370. [Google Scholar] [CrossRef]
- Wood, E.; Nurse, P. Pom1 and cell size homeostasis in fission yeast. Cell Cycle 2013, 12, 3228–3236. [Google Scholar] [CrossRef]
- Martin, S.G. Microtubule-dependent cell morphogenesis in the fission yeast. Trends Cell Biol. 2009, 19, 447–454. [Google Scholar] [CrossRef]
- Moseley, J.B.; Mayeux, A.; Paoletti, A.; Nurse, P. A spatial gradient coordinates cell size and mitotic entry in fission yeast. Nature 2009, 459, 857–860. [Google Scholar] [CrossRef]
- Taminato, A.; Bagattini, R.; Gorjão, R.; Chen, G.; Kuspa, A.; Souza, G.M. Role for YakA, cAMP, and Protein Kinase A in Regulation of Stress Responses of Dictyostelium discoideum Cells. Mol. Biol. Cell 2002, 13, 2266–2275. [Google Scholar] [CrossRef]
- Zhou, X.; Ye, J.; Zheng, L.; Jiang, P.; Lu, L. A new identified suppressor of Cdc7p/SepH kinase, PomA, regulates fungal asexual reproduction via affecting phosphorylation of MAPK-HogA. PLoS Genet. 2019, 15, e1008206. [Google Scholar] [CrossRef]
- Shin, J.H.; Kim, H.Y.; Fu, T.; Lee, K.H.; Kim, K.S. CsPOM1, a DYRK Family Kinase, Plays Diverse Roles in Fungal Development, Virulence, and Stress Tolerance in the Anthracnose Pathogen Colletotrichum scovillei. Front. Cell. Infect. Microbiol. 2022, 12, 861915. [Google Scholar] [CrossRef] [PubMed]
- Gerganova, V.; Bhatia, P.; Vincenzetti, V.; Martin, S.G. Direct and indirect regulation of Pom1 cell size pathway by the protein phosphatase 2C Ptc1. Mol. Biol. Cell 2021, 32, 703–711. [Google Scholar] [CrossRef] [PubMed]
- Hachet, O.; Berthelot-Grosjean, M.; Kokkoris, K.; Vincenzetti, V.; Moosbrugger, J.; Martin, S.G. A Phosphorylation Cycle Shapes Gradients of the DYRK Family Kinase Pom1 at the Plasma Membrane. Cell 2011, 145, 1116–1128. [Google Scholar] [CrossRef] [PubMed]
- MacAlpine, J.; Liu, Z.; Hossain, S.; Whitesell, L.; Robbins, N.; Cowen, L.E. DYRK-family kinases regulate Candida albicans morphogenesis and virulence through the Ras1/PKA pathway. mBio 2023, 14, e02183-23. [Google Scholar] [CrossRef] [PubMed]
- Yaakoub, H.; Latgé, J.P.; Papon, N. Central Sugar Metabolism and the Cell Wall. mBio 2022, 13, e0210422. [Google Scholar] [CrossRef]
- Lima, S.L.; Colombo, A.L.; de Almeida Junior, J.N. Fungal Cell Wall: Emerging Antifungals and Drug Resistance. Front. Microbiol. 2019, 10, 2573. [Google Scholar] [CrossRef]
- Hundertmark, M.; Hincha, D.K. LEA (Late Embryogenesis Abundant) proteins and their encoding genes in Arabidopsis thaliana. BMC Genom. 2008, 9, 118. [Google Scholar] [CrossRef]
- Díaz-Jiménez, D.F.; Pérez-García, L.A.; Martínez-Álvarez, J.A.; Mora-Montes, H.M. Role of the Fungal Cell Wall in Pathogenesis and Antifungal Resistance. Curr. Fungal Infect. Rep. 2012, 6, 275–282. [Google Scholar] [CrossRef]
- Rangel, D.E.; Anderson, A.J.; Roberts, D.W. Evaluating physical and nutritional stress during mycelial growth as inducers of tolerance to heat and UV-B radiation in Metarhizium anisopliae conidia. Mycol. Res. 2008, 112, 1362–1372. [Google Scholar] [CrossRef]
- Iovine, B.; Iannella, M.L.; Bevilacqua, M.A. Damage-specific DNA binding protein 1 (DDB1): A protein with a wide range of functions. Int. J. Biochem. Cell Biol. 2011, 43, 1664–1667. [Google Scholar] [CrossRef]
- Malarkey, C.S.; Churchill, M.E. The high mobility group box: The ultimate utility player of a cell. Trends Biochem. Sci. 2012, 37, 553–562. [Google Scholar] [CrossRef] [PubMed]
- Zhang, N.; Kaur, R.; Lu, X.; Shen, X.; Li, L.; Legerski, R.J. The Pso4 mRNA Splicing and DNA Repair Complex Interacts with WRN for Processing of DNA Interstrand Cross-links. J. Biol. Chem. 2005, 280, 40559–40567. [Google Scholar] [CrossRef]
- Mahajan, K.N.; Mitchell, B.S. Role of human Pso4 in mammalian DNA repair and association with terminal deoxynucleotidyl transferase. Proc. Natl. Acad. Sci. USA 2003, 100, 10746–10751. [Google Scholar] [CrossRef] [PubMed]
- Yue, X.; Bai, C.; Xie, D.; Ma, T.; Zhou, P.K. DNA-PKcs: A Multi-Faceted Player in DNA Damage Response. Front. Genet. 2020, 11, 607428. [Google Scholar] [CrossRef] [PubMed]
- Zhang, M.; Wang, L.; Zhong, D. Photolyase: Dynamics and electron-transfer mechanisms of DNA repair. Arch. Biochem. Biophys. 2017, 632, 158–174. [Google Scholar] [CrossRef] [PubMed]
- Kettenbach, A.N.; Deng, L.; Wu, Y.; Baldissard, S.; Adamo, M.E.; Gerber, S.A.; Moseley, J.B. Quantitative phosphoproteomics reveals pathways for coordination of cell growth and division by the conserved fission yeast kinase pom1. Mol. Cell. Proteom. 2015, 14, 1275–1287. [Google Scholar] [CrossRef]
- Padte, N.N.; Martin, S.G.; Howard, M.; Chang, F. The cell-end factor pom1p inhibits mid1p in specification of the cell division plane in fission yeast. Curr. Biol. 2006, 16, 2480–2487. [Google Scholar] [CrossRef]
- Harris, S.D. Septum formation in Aspergillus nidulans. Curr. Opin. Microbiol. 2001, 4, 736–739. [Google Scholar] [CrossRef]
- Meyer, M.; Cox, J.A.; Hitchings, M.D.T.; Burgin, L.; Hort, M.C.; Hodson, D.P.; Gilligan, C.A. Quantifying airborne dispersal routes of pathogens over continents to safeguard global wheat supply. Nat. Plants 2017, 3, 780–786. [Google Scholar] [CrossRef]
- Vidal, T.; Lusley, P.; Leconte, M.; de Vallavieille-Pope, C.; Huber, L.; Saint-Jean, S. Cultivar architecture modulates spore dispersal by rain splash: A new perspective to reduce disease progression in cultivar mixtures. PLoS ONE 2017, 12, e0187788. [Google Scholar] [CrossRef]
- Huang, M.; Hebert, A.S.; Coon, J.J.; Hull, C.M. Protein Composition of Infectious Spores Reveals Novel Sexual Development and Germination Factors in Cryptococcus. PLoS Genet. 2015, 11, e1005490. [Google Scholar] [CrossRef] [PubMed]
- Wong, H.J.; Mohamad-Fauzi, N.; Rizman-Idid, M.; Convey, P.; Alias, S.A. Protective mechanisms and responses of micro-fungi towards ultraviolet-induced cellular damage. Polar Sci. 2019, 20, 19–34. [Google Scholar] [CrossRef]
- Alves, R.T.; Bateman, R.P.; Prior, C.; Leather, S.R. Effects of simulated solar radiation on conidial germination of Metarhizium anisopliae in different formulations. Crop Prot. 1998, 17, 675–679. [Google Scholar] [CrossRef]
- Latgé, J.P. The cell wall: A carbohydrate armour for the fungal cell. Mol. Microbiol. 2007, 66, 279–290. [Google Scholar] [CrossRef] [PubMed]
- Gow, N.A.R.; Latge, J.P.; Munro, C.A. The Fungal Cell Wall: Structure, Biosynthesis, and Function. Microbiol. Spectr. 2017, 5, 28513415. [Google Scholar] [CrossRef]
- Estruch, F. Stress-controlled transcription factors, stress-induced genes and stress tolerance in budding yeast. FEMS Microbiol. Rev. 2000, 24, 469–486. [Google Scholar] [CrossRef]
- François, J.; Parrou, J.L. Reserve carbohydrates metabolism in the yeast Saccharomyces cerevisiae. FEMS Microbiol. Rev. 2001, 25, 125–145. [Google Scholar] [CrossRef]
- Rangel, D.E.; Braga, G.U.; Fernandes, É.K.; Keyser, C.A.; Hallsworth, J.E.; Roberts, D.W. Stress tolerance and virulence of insect-pathogenic fungi are determined by environmental conditions during conidial formation. Curr. Genet. 2015, 61, 383–404. [Google Scholar] [CrossRef]
- Ribeiro, G.D.; de Holanda Paranhos, L.; Eleutherio, E.C.A. Trehalose promotes biological fitness of fungi. Fungal Biol. 2024; in press. [Google Scholar] [CrossRef]
- Li, C.; Zhang, Q.; Xia, Y.; Jin, K. MaNmrA, a Negative Transcription Regulator in Nitrogen Catabolite Repression Pathway, Contributes to Nutrient Utilization, Stress Resistance, and Virulence in Entomopathogenic Fungus Metarhizium acridum. Biology 2021, 10, 1167. [Google Scholar] [CrossRef]
- Li, C.; Zhang, Q.; Xia, Y.; Jin, K. MaAreB, a GATA Transcription Factor, Is Involved in Nitrogen Source Utilization, Stress Tolerances and Virulence in Metarhizium acridum. J. Fungi 2021, 7, 512. [Google Scholar] [CrossRef] [PubMed]
- Song, T.; Li, C.; Jin, K.; Xia, Y. The Forkhead Box Gene, MaSep1, Negatively Regulates UV- and Thermo-Tolerances and Is Required for Microcycle Conidiation in Metarhizium acridum. J. Fungi 2024, 10, 544. [Google Scholar] [CrossRef] [PubMed]
- Song, L.; Xue, X.; Wang, S.; Li, J.; Jin, K.; Xia, Y. MaAts, an Alkylsulfatase, Contributes to Fungal Tolerances against UV-B Irradiation and Heat-Shock in Metarhizium acridum. J. Fungi 2022, 8, 270. [Google Scholar] [CrossRef] [PubMed]
- Mohammadi, B.; Safaiyan, A.; Habibi, P.; Moradi, G. Evaluation of the acoustic performance of polyurethane foams embedded with rock wool fibers at low-frequency range; design and construction. Appl. Acoust. 2021, 182, 108223. [Google Scholar] [CrossRef]
- Sinha, R.P.; Häder, D.P. UV-induced DNA damage and repair: A review. Photochem. Photobiol. Sci. 2002, 1, 225–236. [Google Scholar] [CrossRef]
- Yang, H.; Yao, F.; Marti, T.M.; Schmid, R.A.; Peng, R.-W. Beyond DNA Repair: DNA-PKcs in Tumor Metastasis, Metabolism and Immunity. Cancers 2020, 12, 3389. [Google Scholar] [CrossRef]
- Matsuoka, S.; Ballif, B.A.; Smogorzewska, A.; McDonald, E.R., 3rd; Hurov, K.E.; Luo, J.; Bakalarski, C.E.; Zhao, Z.; Solimini, N.; Lerenthal, Y.; et al. ATM and ATR substrate analysis reveals extensive protein networks responsive to DNA damage. Science 2007, 316, 1160–1166. [Google Scholar] [CrossRef]
- Meng, X.; Wang, Q.; Hao, R.; Li, X.; Li, M.; Hu, R.; Du, H.; Hu, Z.; Yu, B.; Li, S. RNA-binding protein MAC5A interacts with the 26S proteasome to regulate DNA damage response in Arabidopsis. Plant Physiol. 2023, 191, 446–462. [Google Scholar] [CrossRef]
- Paronetto, M.P.; Miñana, B.; Valcárcel, J. The Ewing sarcoma protein regulates DNA damage-induced alternative splicing. Mol. Cell 2011, 43, 353–368. [Google Scholar] [CrossRef]
- Blair, R.H.; Horn, A.E.; Pazhani, Y.; Grado, L.; Goodrich, J.A.; Kugel, J.F. The HMGB1 C-Terminal Tail Regulates DNA Bending. J. Mol. Biol. 2016, 428, 4060–4072. [Google Scholar] [CrossRef]
- Bai, Y.; Wang, S.; Zhong, H.; Yang, Q.; Zhang, F.; Zhuang, Z.; Yuan, J.; Nie, X.; Wang, S. Integrative analyses reveal transcriptome-proteome correlation in biological pathways and secondary metabolism clusters in A. flavus in response to temperature. Sci. Rep. 2015, 5, 14582. [Google Scholar] [CrossRef] [PubMed]
- Bhat, S.; Kumar, P.; Kashyap, N.; Deshmukh, B.; Dige, M.S.; Bhushan, B.; Chauhan, A.; Kumar, A.; Singh, G. Effect of heat shock protein 70 polymorphism on thermotolerance in Tharparkar cattle. Vet. World 2016, 9, 113–117. [Google Scholar] [CrossRef] [PubMed]
- Shan, Q.; Ma, F.; Wei, J.; Li, H.; Ma, H.; Sun, P. Physiological Functions of Heat Shock Proteins. Curr. Protein Pept. Sci. 2020, 21, 751–760. [Google Scholar] [CrossRef] [PubMed]
- Tabuchi, Y.; Furusawa, Y.; Kariya, A.; Wada, S.; Ohtsuka, K.; Kondo, T. Common gene expression patterns responsive to mild temperature hyperthermia in normal human fibroblastic cells. Int. J. Hyperth. 2013, 29, 38–50. [Google Scholar] [CrossRef] [PubMed]
- Khandia, R.; Munjal, A.K.; Iqbal, H.M.N.; Dhama, K. Heat Shock Proteins: Therapeutic Perspectives in Inflammatory Disorders. Recent Pat. Inflamm. Allergy Drug Discov. 2017, 10, 94–104. [Google Scholar] [CrossRef]
- Wu, T.; Chen, S.; Xiao, C.; Wang, C.; Pan, Q.; Wang, Z.; Xie, M.; Mao, Z.; Wu, Y.; Tanguay, R.M. Presence of antibody against the inducible Hsp71 in patients with acute heat-induced illness. Cell Stress Chaperones 2001, 6, 113–120. [Google Scholar] [CrossRef]
- Alagar Boopathy, L.R.; Jacob-Tomas, S.; Alecki, C.; Vera, M. Mechanisms tailoring the expression of heat shock proteins to proteostasis challenges. J. Biol. Chem. 2022, 298, 101796. [Google Scholar] [CrossRef]
- Lamoth, F.; Juvvadi, P.R.; Fortwendel, J.R.; Steinbach, W.J. Heat Shock Protein 90 Is Required for Conidiation and Cell Wall Integrity in Aspergillus fumigatus. Eukaryot. Cell 2012, 11, 1324–1332. [Google Scholar] [CrossRef]
- Lazo, G.R.; Stein, P.A.; Ludwig, R.A. A DNA Transformation–Competent Arabidopsis Genomic Library in Agrobacterium. Nat. Biotechnol. 1991, 9, 963–967. [Google Scholar] [CrossRef]
- Schwede, T.; Kopp, J.; Guex, N.; Peitsch, M.C. SWISS-MODEL: An automated protein homology-modeling server. Nucleic Acids Res. 2003, 31, 3381–3385. [Google Scholar] [CrossRef]
- Leclerque, A.; Wan, H.; Abschütz, A.; Chen, S.; Mitina, G.; Zimmermann, G.; Schairer, H. Agrobacterium-mediated insertional mutagenesis (AIM) of the entomopathogenic fungus Beauveria bassiana. Curr. Genet. 2004, 45, 111–119. [Google Scholar] [CrossRef] [PubMed]
- Drexler, C. HTRF® KinEASETM: A new solution for screening serine-threonine kinases. Nat. Methods 2006, 3, I–II. [Google Scholar] [CrossRef]
- Zhao, T.; Wen, Z.; Xia, Y.; Jin, K. The transmembrane protein MaSho1 negatively regulates conidial yield by shifting the conidiation pattern in Metarhizium acridum. Appl. Microbiol. Biotechnol. 2020, 104, 4005–4015. [Google Scholar] [CrossRef] [PubMed]
- Zhang, J.; Wang, Z.; Keyhani, N.O.; Peng, G.; Jin, K.; Xia, Y. The protein phosphatase gene MaPpt1 acts as a programmer of microcycle conidiation and a negative regulator of UV-B tolerance in Metarhizium acridum. Appl. Microbiol. Biotechnol. 2019, 103, 1351–1362. [Google Scholar] [CrossRef] [PubMed]
- Liu, J.; Cao, Y.; Xia, Y. Mmc, a gene involved in microcycle conidiation of the entomopathogenic fungus Metarhizium anisopliae. J. Invertebr. Pathol. 2010, 105, 132–138. [Google Scholar] [CrossRef]
- Li, C.; Xu, D.; Hu, M.; Zhang, Q.; Xia, Y.; Jin, K.J.M.S. MaNCP1, a C2H2 Zinc Finger Protein, Governs the Conidiation Pattern Shift through Regulating the Reductive Pathway for Nitric Oxide Synthesis in the Filamentous Fungus Metarhizium acridum. Microbiol. Spectr. 2022, 10, e00538-22. [Google Scholar] [CrossRef]
- Ming, Y.; Wei, Q.; Jin, K.; Xia, Y. MaSnf1, a sucrose non-fermenting protein kinase gene, is involved in carbon source utilization, stress tolerance, and virulence in Metarhizium acridum. Appl. Microbiol. Biotechnol. 2014, 98, 10153–10164. [Google Scholar] [CrossRef]
- Braga, G.; Flint, S.; Miller, C.; Anderson, A.; Roberts, D. Variability in Response to UV-B among Species and Strains of Metarhizium Isolated from Sites at Latitudes from 61°N to 54°S. J. Invertebr. Pathol. 2001, 78, 98–108. [Google Scholar] [CrossRef]
- Li, J.; Guo, M.; Cao, Y.; Xia, Y. Disruption of a C69-Family Cysteine Dipeptidase Gene Enhances Heat Shock and UV-B Tolerances in Metarhizium acridum. Front. Microbiol. 2020, 11, 849. [Google Scholar] [CrossRef]
- Zhou, J.; Wang, S.; Xia, Y.; Peng, G. MaAzaR, a Zn2Cys6/Fungus-Specific Transcriptional Factor, Is Involved in Stress Tolerance and Conidiation Pattern Shift in Metarhizium acridum. J. Fungi 2024, 10, 468. [Google Scholar] [CrossRef]

Disclaimer/Publisher’s Note: The statements, opinions and data contained in all publications are solely those of the individual author(s) and contributor(s) and not of MDPI and/or the editor(s). MDPI and/or the editor(s) disclaim responsibility for any injury to people or property resulting from any ideas, methods, instructions or products referred to in the content. |
© 2024 by the authors. Licensee MDPI, Basel, Switzerland. This article is an open access article distributed under the terms and conditions of the Creative Commons Attribution (CC BY) license (https://creativecommons.org/licenses/by/4.0/).
Share and Cite
Zhang, Y.; Song, L.; Xia, Y. MaPom1, a Dual-Specificity Tyrosine Phosphorylation-Regulated Kinase, Positively Regulates Thermal and UV-B Tolerance in Metarhizium acridum. Int. J. Mol. Sci. 2024, 25, 11860. https://doi.org/10.3390/ijms252211860
Zhang Y, Song L, Xia Y. MaPom1, a Dual-Specificity Tyrosine Phosphorylation-Regulated Kinase, Positively Regulates Thermal and UV-B Tolerance in Metarhizium acridum. International Journal of Molecular Sciences. 2024; 25(22):11860. https://doi.org/10.3390/ijms252211860
Chicago/Turabian StyleZhang, Yu, Lei Song, and Yuxian Xia. 2024. "MaPom1, a Dual-Specificity Tyrosine Phosphorylation-Regulated Kinase, Positively Regulates Thermal and UV-B Tolerance in Metarhizium acridum" International Journal of Molecular Sciences 25, no. 22: 11860. https://doi.org/10.3390/ijms252211860
APA StyleZhang, Y., Song, L., & Xia, Y. (2024). MaPom1, a Dual-Specificity Tyrosine Phosphorylation-Regulated Kinase, Positively Regulates Thermal and UV-B Tolerance in Metarhizium acridum. International Journal of Molecular Sciences, 25(22), 11860. https://doi.org/10.3390/ijms252211860

